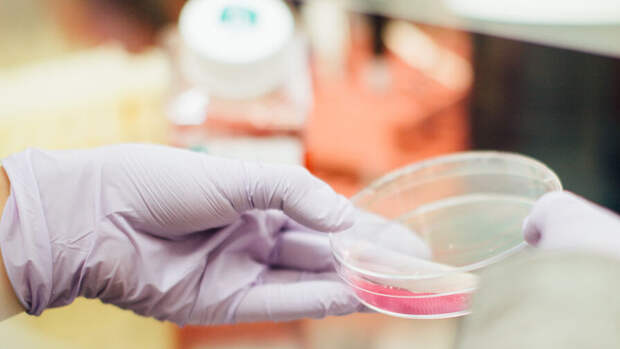

Ученые из Вятского Государственного Университета создали дрожжи с человеческим геном в ДНК для производства препарата для регенеративной медицины. Об этом пишет РИА Новости.
Биологи из ВятГУ превратили дрожжи в фабрики по производству тромбоцитарного фактора роста. Это вещество вырабатывается и в человеческом организме, но в небольших количествах.
Его перепроизводство может привести к возникновению рака или быстрому развитию атеросклероза. Но врачи научились применять его для стимуляции регенерации тканей при трофических язвах у больных диабетом и в ортопедии, например, при повреждении связок у спортсменов.Ген, ответственный за синтез этого вещества, ученые внедрили в ДНК дрожжей Pichia pastoris — это сделало микробы способными производить человеческий белок в присутствии метилового спирта. Полученное вещество ученые очищали с помощью хроматографии. Авторы работы уже получили опытный образец препарата в форме геля с чистотой 98% и содержанием фактора роста 100 мкг/мл.
Авторы разработки подтвердили, что их технология имеет аналоги, но за рубежом. Это делает нашу страну уязвимой: при сокращении поставок может возникнуть дефицит важного препарата. Кроме того, российское производство будет дешевле и в два-три раза эффективнее.
Свежие комментарии